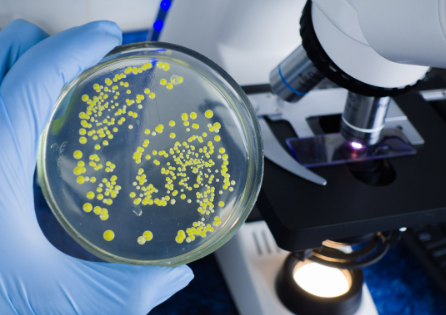
Foto - Kara Veba! Milyonları öldüren hastalığın nasıl yayıldığı bulundu
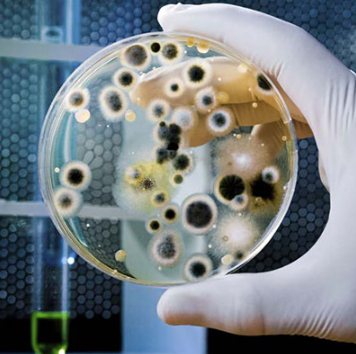
Foto - Kara Veba! Milyonları öldüren hastalığın nasıl yayıldığı bulundu

Kara Veba! Milyonları öldüren hastalığın nasıl yayıldığı bulundu
Orta Çağ Avrupa'sında 25 milyon kişinin ölümüne yol açtığı tahmin edilen veba salgınının, düşünülenden farklı bir şekilde yayıldığı ortaya çıktı.
Orta Çağ Avrupa'sında 25 milyon kişinin ölümüne yol açtığı tahmin edilen veba salgınının, düşünülenden farklı bir şekilde yayıldığı ortaya çıktı.
Kara Ölüm diye bilinen vebaya yol açan Yersinia pestis adlı bakteri, kemirgen ve pireler arasında doğal yolla yayılıyor. Pirelerin insanları ısırarak hastalığı bulaştırdığı bilindiğinden, veba salgınlarına bunun yol açtığı tahmin ediliyor.
PLOS Biology adlı hakemli dergide salı günü yayımlanan araştırmaya göre başka bir böcek de Avrupa'daki salgının yayılmasında pireler kadar önemli bir rol oynamış olabilir. İnsan kanıyla beslenen vücut bitinin, Yersinia pestis bakterisini taşıyabildiği bilinse de bunu bir salgına yol açacak kadar yayamayacağı düşünülüyordu.
Araştırmanın kıdemli yazarı Joe Hinnebusch "Avrupa'daki Kara Ölüm salgınının tıbbi tarihi hakkında uzun süredir devam eden bir tartışma var" diyor.
Bilim insanları bu belirsizliği ortadan kaldırmak adına vücut bitinin bakteriyi yayma hızını laboratuvarda inceledi.
İnsan derisinin ısısını taklit eden yapay bir derideki Yersinia pestis içeren kan örnekleriyle beslenen bitler enfekte oldu. Örneklerdeki bakteri seviyesi, gerçek insan vakalarına yakındı.
Ardından bu bitler, steril bir yapay deriden kan emerek bakteriyi düzenli bir şekilde yaymaya başladı.
Araştırmacılar bakterinin, bitlerdeki Pawlowsky bezlerini enfekte edebildiğini de saptadı. Bu tükürük bezleri, enfeksiyonu sadece sindirim sisteminde taşıyan bitlerden daha istikrarlı bir şekilde patojeni bulaştırdı.
Bezlerin salgıladığı bir tür kayganlaştırıcı maddenin, bakteriyi bitlerin ağız kısmına bulaştırdığı düşünülüyor. Bilim insanlarına göre bu bitler insanları ısırarak hastalığı bulaştırmış ve salgının patlak vermesinde rol oynamış olabilir.
Hinnebusch şöyle diyor: “Birinci gün gibi erken bir zamanda bakterinin bulaştığı görülüyor fakat enfeksiyondan sonraki üç ila 7 gün arasında daha fazla bakteri bulaştı.”
WhatsApp İhbar Hattı
+90 (553) 313 94 23